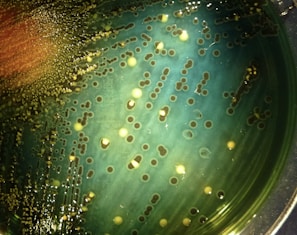

Compartir
Espacio para compartir recetas y tips para mejorar la alimentación.








Medbiota
Atención integral a la salud.
consultas
Contacto
© 2025. All rights reserved.
Espacio para compartir recetas y tips para mejorar la alimentación.

Atención integral a la salud.
consultas
Contacto
© 2025. All rights reserved.
